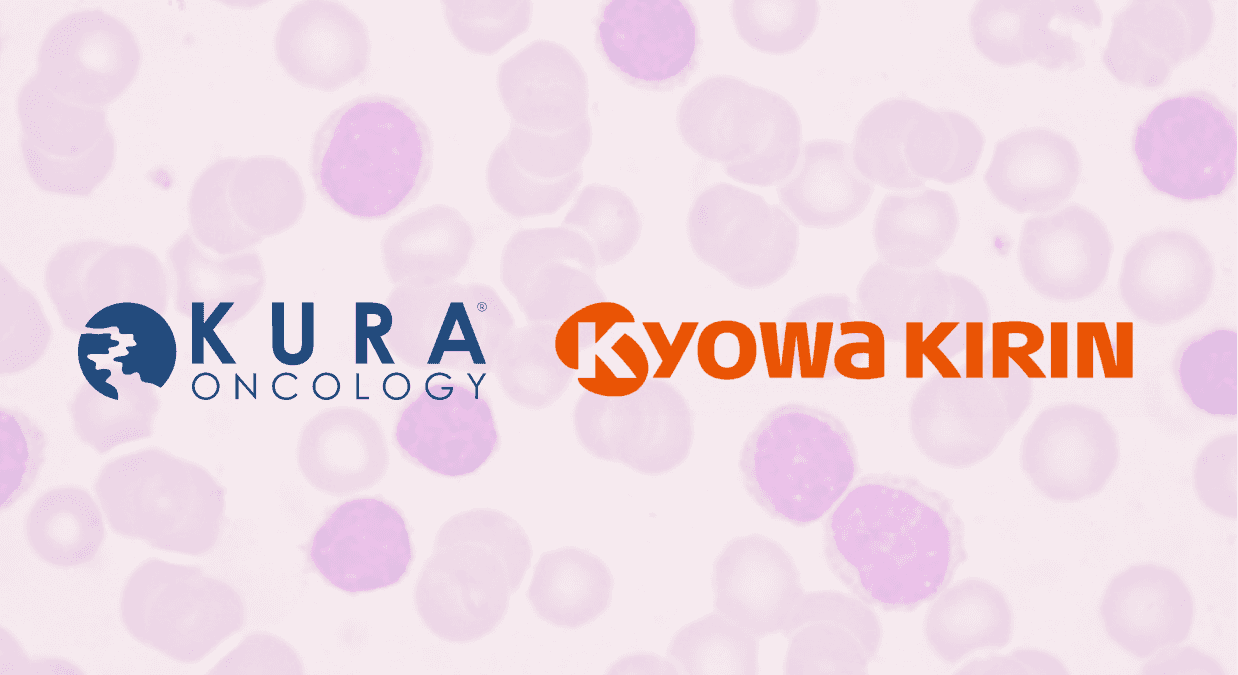
Kura Oncology And Kyowa Kirin Report FDA Acceptance & Priority Review Of New Drug Application for Ziftomenib In Adults With Relapsed Or Refractory NPM1-Mutant Acute Myeloid Leukemia

Kura Oncology And Kyowa Kirin Report FDA Acceptance & Priority Review Of New Drug Application for Ziftomenib In Adults With Relapsed Or Refractory NPM1-Mutant Acute Myeloid Leukemia
FDA accepts NDA for ziftomenib in NPM1-mutant AML with Priority Review and a PDUFA date of November 30, 2025.
Breaking News
Jun 02, 2025
Vaibhavi M.

Kura Oncology, Inc. and Kyowa Kirin Co., Ltd. have announced that the U.S. Food and Drug Administration (FDA) has accepted the New Drug Application (NDA) for ziftomenib. This application seeks full approval for the use of ziftomenib in treating adult patients with relapsed or refractory acute myeloid leukemia (AML) that carries a nucleophosmin 1 (NPM1) mutation. The FDA has granted the application Priority Review status and has set a Prescription Drug User Fee Act (PDUFA) target action date of November 30, 2025.
The NDA submission is based on data from the Phase 2 KOMET-001 registrational trial (NCT #04067336), which evaluated ziftomenib in patients with NPM1-mutant relapsed or refractory AML. The trial met its primary endpoint by demonstrating a statistically significant rate of complete remission (CR) and complete remission with partial hematologic recovery (CRh). Ziftomenib showed a favorable safety profile, with minimal myelosuppression and only 3% of patients discontinuing treatment due to side effects related to the drug. The safety and tolerability results were consistent with previous findings, supporting a strong benefit-risk profile for the therapy.
Troy Wilson, Ph.D., J.D., President and Chief Executive Officer of Kura Oncology, said in a statement, “The FDA’s acceptance of our New Drug Application marks a significant milestone for Kura and Kyowa Kirin and, more importantly, for patients living with this genetic subset of AML, who face an aggressive form of the disease with few treatment options. This achievement reflects the strength of the clinical data for ziftomenib as well as the incredible commitment of our teams. Along with our partners at Kyowa Kirin, we look forward to continuing to work closely with the FDA throughout the review process and to prepare for the anticipated launch of this treatment, which holds potential to meaningfully impact the lives of patients and their families.”
Takeyoshi Yamashita, Ph.D., Executive Vice President and Chief Medical Officer of Kyowa Kirin, stated, “Adult R/R NPM1-m AML patients face a significantly poor prognosis, highlighting the urgent need for innovative treatment options that can improve their outcomes. The acceptance of this NDA is a crucial step in our ongoing efforts to explore and evaluate various therapeutic strategies for AML through our comprehensive clinical trials. Our dedicated teams at Kyowa Kirin and Kura are fully committed to working tirelessly to ensure that, once approved, ziftomenib is made available to AML patients as quickly as possible. We recognize the importance of this endeavor and are excited about the possibility of making a meaningful impact on the lives of those affected by this challenging disease.”
The KOMET-001 trial was designed to assess the clinical activity, safety, and tolerability of ziftomenib. It is currently the only investigational treatment for this patient population that has received Breakthrough Therapy Designation from the FDA. In addition to this designation, ziftomenib has also been granted Fast Track and Orphan Drug Designations, reflecting the need for effective therapies in this specific form of AML. Detailed results from the KOMET-001 trial have been selected for an oral presentation at the 2025 American Society of Clinical Oncology (ASCO) Annual Meeting, scheduled for June 2. An encore presentation is also planned for the 2025 European Hematology Association (EHA) Congress.